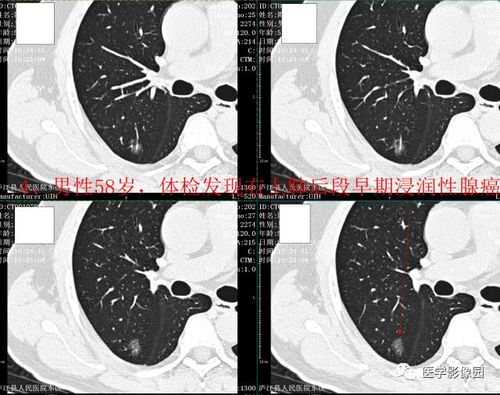
头晕引起的肿瘤有哪些 头晕引起的肿瘤有哪些

头晕引起的肿瘤有哪些
胃癌 2025-12-15 09:20胃癌治疗www.zhongliuw.cn
头晕,这一看似平常的症状背后,却可能隐藏着诸多疾病的可能,特别是颅内肿瘤或其他系统肿瘤的颅内转移。让我们一起深入了解一下可能导致头晕的主要肿瘤类型及其相关特点。
颅内肿瘤是头晕的一个重要诱因。脑干肿瘤,位于脑部重要区域,一旦出现肿瘤便可能引发眩晕,这种眩晕感伴随的常常是颅内压增高的明显症状,如头痛和呕吐。听神经瘤,即我们常说的神经鞘瘤,位于桥小脑角区域,它的早期症状表现为单侧耳鸣和听力下降,随着病情的发展逐渐出现眩晕和头晕等症状。小脑肿瘤虽然头晕症状较为常见,但通常表现较轻,可能会影响到平衡感或步态。而第四脑室肿瘤则可能突然引发眩晕并伴有急性颅内压增高的症状。脑膜瘤和胶质瘤则属于生长缓慢的良性肿瘤和恶性程度较高的原发性脑肿瘤,当体积增大时可能会压迫脑组织,导致头晕等一系列症状。
除了颅内肿瘤外,其他系统的肿瘤也有可能发生颅内转移。肺癌、乳腺癌等转移瘤一旦转移到脑部可能会形成多发病灶,导致颅内压增高而出现头晕等症状。血液系统肿瘤如淋巴瘤、白血病等也可能通过影响脑膜或造血功能间接导致头晕。
头晕的原因远不止于此。许多非肿瘤性疾病也可能引起头晕的症状。比如耳石症、梅尼埃病等耳源性病症;高血压、椎基底动脉供血不足等心脑血管性疾病;以及焦虑、睡眠障碍等精神心理因素都可能导致头晕的出现。在面对头晕这一症状时,我们需要多方面考虑可能的原因。
当头晕持续存在并伴随其他神经系统症状时,如呕吐、视力下降或肢体无力等,强烈建议您尽早就医进行专业的诊断。通过头部MRI或CT等先进的医疗技术,我们可以更准确地确定病因并进行针对性的治疗。毕竟,健康无价,预防胜于治疗。在面对身体的不适时,及时寻求医疗帮助是我们最明智的选择。
上一篇:血小板低会是什么肿瘤
下一篇:没有了